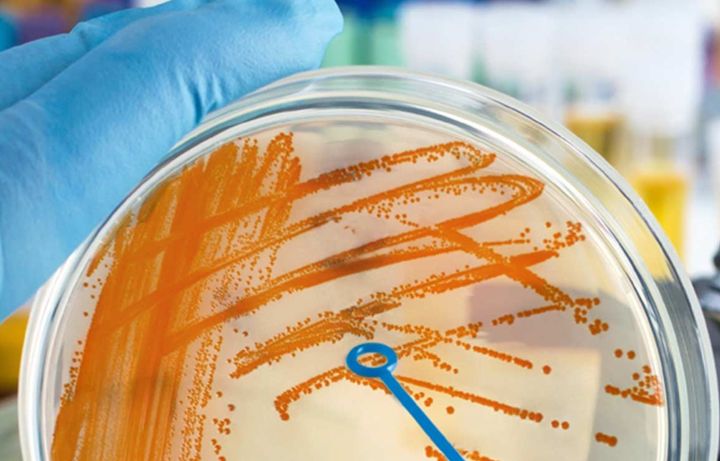
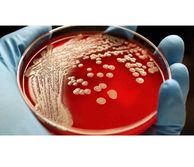

Bioscience-cores
The seven facilities within the biosciences core offer services and tools including Cell/Tissue Culture, Histology, Microscopy, Genomics, Microbiology, Flow Cytometry, and Mass Spectrometry.
BioCores
Designated laboratories
The department houses a number of highly specialist designated laboratories which adhere to strict Home Office , AAALAC and college requirements.
These highly restricted laboratories are controlled in access, have a strict training regime and require office licences to be granted prior to work commencing, on top of the otherwise required standard operating procedures and risk assessments. The laboratories are managed and housed within the department who work closely with the central CBS facility and the Home office to ensure that the facilities are running to the highest standards and that all licences and training is up to date and authorised.

The home of the Molecular Bioengineering teaching laboratory
RCS1, 108
Equipt with all specialist equipment and support led by Joel Eustaquio

The definition of biological material includes biological agents, such as:
- cell cultures
- viruses
- bacteria
- fungi
- protozoa
- prions
and substances that do or are likely to contain such biological agents, with harmful properties including:
- pathogenicity and virulence
- allergenicity
- oncogenicity
- biotoxicity
Managing biosafety and biosecurity
Biorisk management covers the processes and steps for researchers and students to take to control risks of:
- direct or indirect exposure of people to harmful biological materials
- releasing environmentally harmful biological materials
- malicious use of pathogens and biotoxins
- Visit https://www.imperial.ac.uk/safety/safety-by-topic/laboratory-safety/biological-safety/risk-assessment-database-and-register-radar/ and make sure you download the last version of the relevant risk assessments for biological and chemical risks. The Bio1 form is the generic biological risk assessment form and covers tissue, cells, body fluids and excreta both genetically modified (GM), and non-GM.
- Visit https://www.imperial.ac.uk/safety/safety-by-topic/laboratory-safety/chemical-safety/risk-assessment-for-hazardous-chemicals/ to download the relevant chemical risk assessment if needed
- Fill the forms and send to Miguel Hermida for review. You might be asked to modify it accordingly before it is approved by the Department’s BSO
- Create a RADAR entry for the relevant risk type. These entries must be submitted by the PI. Instructions can be found here: https://www.imperial.ac.uk/safety/safety-by-topic/laboratory-safety/biological-safety/risk-assessment-database-and-register-radar/#:~:text=the%20Reporting%20function-,I%20want%20to...%3F,-Expand%20all
Register details about you and your work - RADAR
You must register and maintain details about you and your work with the University's Biosafety team if you are a staff member, student or visitor whose work could potentially expose you to hazardous biological material and complete the mandatory and any optional biosafety training modules available from our training webpage. Biological safety | Administration and support services | Imperial College London
Investigators must submit risk assessments (Bio1) of their work with human pathogens, specific animal pathogens, other potenitally infectious materials, genetically modified organisms and biotoxins for review, registration and regulator notification before work can start.